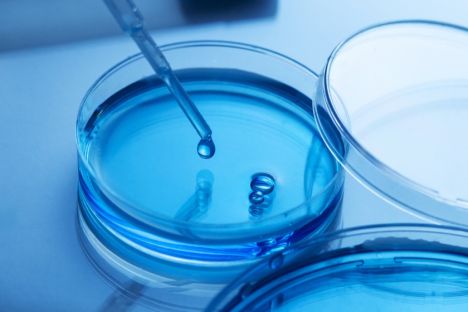
masks

Gydymas
Skaityti daugiau

Šių metų Pasaulio sveikatos organizacijos (PSO) pasirinktas šūkis „Kartu dėl sveikatos. Palaikykite mokslą“ („Together for health. Stand with science“) kviečia prisiminti mokslo svarbą sveikatos srityje ir iš naujo permąstyti visuomenės pasitikėjimą medicina, atkurti pasitikėjimą mokslu ir remti mokslu pagrįstus sprendimus sveikesnei ateičiai.
Įvairenybės
Skaityti daugiau
Farmacijos naujienos
Skaityti daugiau

Lietuvoje gyventojų įsitraukimas į ligų prevencijos programas vis dar yra nepakankamas – nemaža visuomenės dalis vengia reguliariai tikrintis sveikatą. Valstybinės ligonių kasos (VLK) užsakymu atliktas gyventojų nuomonės tyrimas atskleidė pagrindines tokios elgsenos priežastis ir parodė, kas galėtų paskatinti žmones aktyviau rūpintis savo sveikata prevenciškai.
Sveikata
Skaityti daugiau

Nors onkologinės ligos Lietuvoje paliečia daugybę šeimų, apie lengvai prieinamą priemonę, galinčią palengvinti pacientų kasdienybę, žino per mažai žmonių. Naujos apklausos duomenimis, net du trečdaliai per pastaruosius penkerius metus sirgusių ar su onkologine liga artimoje aplinkoje susidūrusių žmonių nėra girdėję apie specialios medicininės paskirties maisto produktus, skirtus būtent tokiems pacientams.
Padėk sau
Skaityti daugiau

Velykų stalas dažnai neįsivaizduojamas be gausos patiekalų, tačiau vaistininkai ragina į šventes pažvelgti atsakingiau. Virti kiaušiniai, mišrainės, mėsa ar užtepėlės po švenčių dažnai dar lieka šaldytuve. Vis dėlto net ir tvarkingai atrodantis maistas po kelių dienų gali būti jau nesaugus vartoti, todėl verta iš anksto įsivertinti realius poreikius ir laikytis saiko.
Grožis
Skaityti daugiau

Krūtų plastikos tendencijos keičiasi. Pacientės vis dažniau renkasi natūraliau atrodantį rezultatą, mažesnius implantus ir individualiai pritaikytus sprendimus. Plastikos chirurgė aptaria, kaip keičiasi požiūris į plastinę chirurgiją, kokią įtaką daro socialiniai tinklai, kas dažniausiai ryžtasi operacijoms ir kokie mitai apie implantus vis dar išlieka.